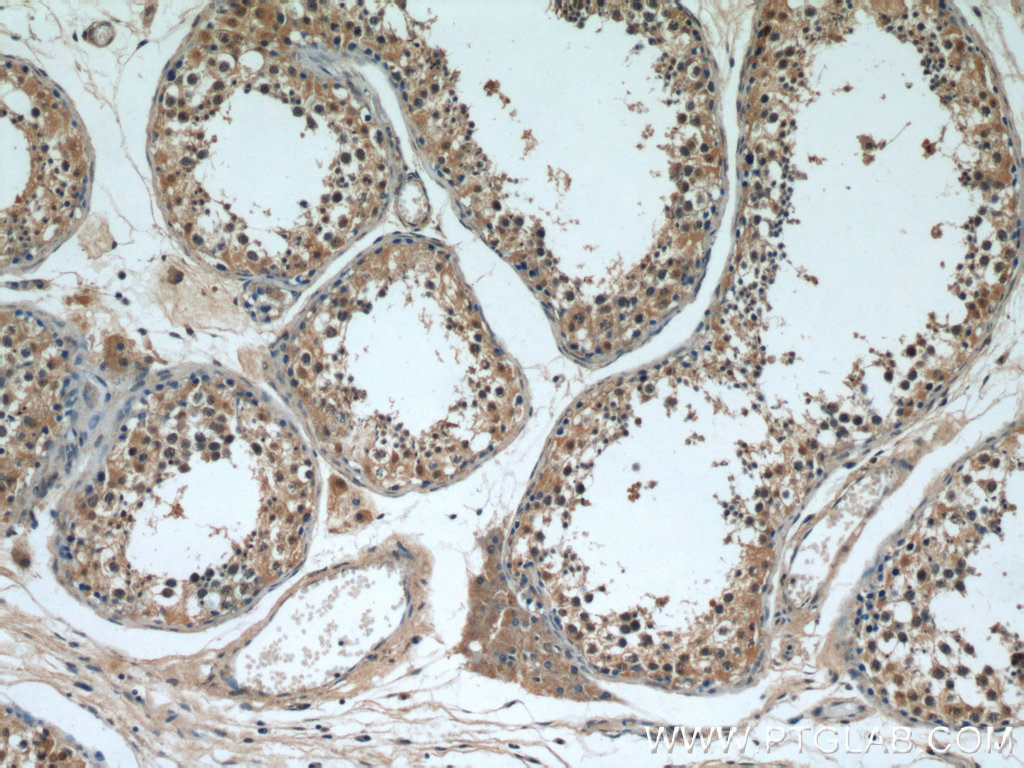

验证数据展示
发表文章中的应用
| WB | See 1 publications below |
产品信息
55311-1-AP targets PI3K p87 in WB, ELISA applications and shows reactivity with human, mouse samples.
| 经测试应用 | ELISA Application Description |
| 文献引用应用 | WB |
| 经测试反应性 | human, mouse |
| 文献引用反应性 | human, mouse |
| 免疫原 |
Peptide 种属同源性预测 |
| 宿主/亚型 | Rabbit / IgG |
| 抗体类别 | Polyclonal |
| 产品类型 | Antibody |
| 全称 | phosphoinositide-3-kinase, regulatory subunit 6 |
| 别名 | C17orf38, HsT41028, p84, p87 PI3K adapter protein, p87(PIKAP), p87PIKAP, PI3K p87, PIK3R6 |
| 计算分子量 | 84 kDa |
| GenBank蛋白编号 | NM_001010855 |
| 基因名称 | PIK3R6 |
| Gene ID (NCBI) | 146850 |
| 偶联类型 | Unconjugated |
| 形式 | Liquid |
| 纯化方式 | Antigen affinity purification |
| UNIPROT ID | Q5UE93 |
| 储存缓冲液 | PBS with 0.02% sodium azide and 50% glycerol, pH 7.3. |
| 储存条件 | Store at -20°C. Aliquoting is unnecessary for -20oC storage. |
背景介绍
PIK3R6, also named as C17orf38 and p87PIKAP, is a regulatory subunit of the PI3K gamma complex. It acts as an adapter to drive activation of PIK3CG by G beta gamma proteins. This antibody is specific to PIK3R5.